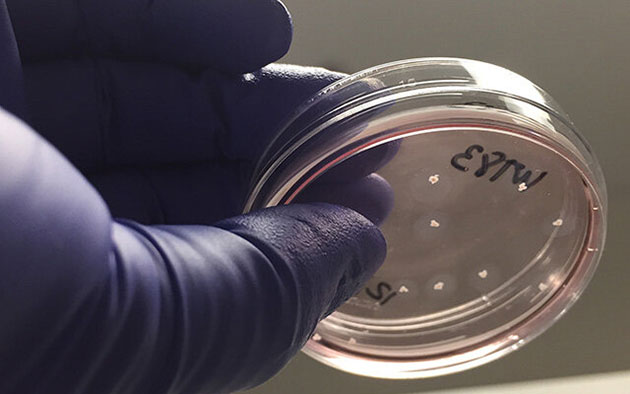

Mini-Gehirne im Labor zeigen Hirnaktivität wie Frühchen

Copyright: UC San Diego Health Sciences
San Diego (USA) – Bei sogenannten Gehirn-Organoiden handelt es sich um 3D-Zellmodelle, die zur Erforschung von Aspekten des menschlichen Gehirns unter Laborbedingungen gezüchtet werden. Während diese “Mini-Hirne” bislang keine kognitiven Funktionen replizierten und „nur“ zur Erforschung der Hirnentwicklung und molekularer Krankheitsauslöser dienen sollen, haben US-Forscher nun in einigen nun optimierten Hirn-Organoiden neurale Netzwerk-Aktivität in Form elektrischer Impulse erzeugt, wie sie der von Hirnsignalen von zu früh geborenen Kindern – sogenannten Frühchen – gleicht.
Wie das Team aus Neurologen an der University of California San Diego aktuell im Fachjournal “Cell Stem Cell ” (DOI: 10.1016/j.stem.2019.08.002) berichtet, seien die Hirnaktivitätsmuster der von ihnen „optimierten Mini-Hirne“ kaum von Frühchen zu unterscheiden, die dreieinhalb Monate vor dem eigentlichen Geburtstermin zur Welt kamen. Selbst ein auf künstlicher Intelligenz basierender Algorithmus, bewertete die EEG-Signale als die entsprechend zu früh geborener Babies.
Auf diese Weise können Mediziner und Neurologen nun mentale Krankheiten erforschen, die nicht das Ergebnis von offenkundigen physiologischen Veränderungen sind oder zu diesen führen, stattdessen aber auf Störungen in der Aktivität des Hirnzellen-Netzwerks zurückgehen, darunter Autismus oder Epilepsie. Bislang gab es für viele dieser Zustände keine relevanten Labor- oder Tiermodelle.
www.grenzwissenschaft-aktuell.de
+ HIER können Sie den täglichen kostenlosen GreWi-Newsletter bestellen +
“Wir konnten es zunächst selbst nicht glauben und dachten, dass unsere Elektroden nicht richtig funktionieren würden“, erinnert sich der Hauptautoren des Fachartikels, Dr. Alysson R. Muotri. „Die Daten waren so klar, dass viele von uns zunächst selbst skeptisch waren.“
Hintergrund
Die Herstellung von Gehirn-Organoiden beginnt mit einer Hautprobe eines Erwachsenen. Im Labor werden deren Hautzellen dann in sogenannten pluripotente Stammzellen (iPSCs) induziert und können dann zu jeder gewünschten Zellart spezialisiert entwickelt werden. In diesem Fall zu Hirnzellen, beispielsweise also unterschiedlichen Arten von Neuronen und Gliazellen. Mit derartigen „Mini-Hirnen“ konnte bereits der erste experimentelle Nachweis für die vom Zika-Virus hervorgerufenen Geburtsfehler erbracht werden; und erst kürzlich schickte Muotris Team Gehirn-Organoide zur Internationalen Raumstation, um hier die Auswirkungen von Mikrogravitation auf die Hirnentwicklung für zukünftige Weltraummissionen fernab der Erde zu untersuchen.
Verantwortlich für die zwar angestrebte aber zunächst dennoch unerwartet komplexe Hirnaktivität seien unter anderem eine bestimmte Form von für Primaten spezifische Neuronen, sog. GABAergische Neuronen, wie sie bislang noch nie im Labor erzeugt werden konnten. Laut Muotri, handelt es sich bei diesen Zellen um die Grundlagen der komplexen Entwicklung neuraler Netzwerke.
Trotz der menschenartigen Hirnsignale seien aber auch die nun “optimierten Mini-Hirne“ nicht in der Lage, die Funktionen etwa des Kortex eines Babies, zu übernehmen. Zugleich schränkt der Wissenschaftler aber ein, dass man “bislang noch keinen Weg kenne, (eventuell vorhandenes) Bewusstsein oder Empfindungsvermögen zu messen.“
Copyright: UC San Diego Health Sciences
Bislang können die Gehirn-Organoide zwar mehrere Jahre im Labor am “Leben” erhalten werden, ihren Aktivitätshöhepunkt erreichen die Miniaturhirne allerdings mit neun Monaten. Als Gründe hierfür nennen die Wissenschaftler u.a. die für die weitere Ausreifung der Neuronen fehlenden Blutgefäße.
„Je besser die Gehirn-Organoide das menschliche Gehirn replizieren können, desto weniger sind Wissenschaftler auf Tiermodelle und Fötus-Gewebe angewiesen, um menschliche Krankheiten besser zu verstehen und behandeln zu können“, erläutert Muotri die Experimente und führt dazu weiter aus: „Bislang ersetzt unsere Arbeit diese Methoden noch nicht ganz, aber sie stellen jetzt schon eine atraktive und potentielle Alternative dazu dar.“
[video_player type=“youtube“ youtube_show_title_bar=“Y“ style=“1″ dimensions=“560×315″ width=“560″ height=“315″ align=“center“ margin_top=“0″ margin_bottom=“20″ ipad_color=“black“]aHR0cHM6Ly95b3V0dS5iZS9ya3BvN1I4VU9sYw==[/video_player]
Tatsächlich versichert Muotri abschließend, dass sich die Mini-Labor-Hirne deutlich von einem funktionsfähigen menschlichen Gehirn unterscheiden. „Zum einen sind sie um ein Vielfaches kleiner als das Gehirn eines ausgewachsenen Menschen, zum anderen verfügen sie über keine Hirnhälften oder Blutgefäße und sie sind nicht von einem sie schützenden Schädel und anderem Gewebe umgeben. Wir sind also noch weit davon entfernt, funktionale menschliche Gehirne im Labor zu erzeugen.“
Quelle: UC San Diego
© grenzwissenschaft-aktuell.de